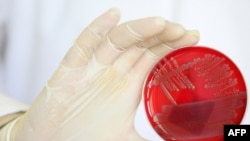
Бактерія Е.coli

Іспанія нарікає на щотижневі збитки розміром 200 мільйонів євро, про 80 мільйонів євро заявляють Нідерланди, 4 мільйони – Бельгія, 3 – у Португалії. Овочівники Румунії, Франції та інших аграрних держав теж нарікають на суттєве падіння продажу їхньої продукції. Криза, яку переживають місцеві землероби, поширилася по всій об’єднаній Європі. До цього ще слід додати ембарго, накладене Росією на всі європейські овочі, яке у Європі називають непропорційним і вимагають негайного скасування.
Все це наслідок передчасного оприлюднення результатів пошуку джерела епідемії, викликаної невідомим донині різновидом кишкової бактерії, яка вже призвела до загибелі понад двох десятків людей.
Екстрена нарада щодо компенсацій та джерела епідемії
Тим часом, зібравшись у Люксембурзі, міністри сільського господарства ЄС шукали шляхи покращення ситуації на ринку та методи компенсації збитків, завданих овочівникам падінням попиту на їхню продукцію. Єврокомісар з питань сільського господарства й розвитку села Дачан Чолош прибув на зустріч із міністрами з пропозицією надати аграріям компенсацію у розмірі 150 мільйонів євро.
«Ми запропонували фінансовий пакет компенсації у розмірі 150 мільйонів. Після дискусій із представниками країн-членів, які попросили збільшити цю суму, я пообіцяв переглянути ці цифри й надати нову пропозицію, можливо вже завтра», – зауважив комісар.
Інша пропозиція – розширити так званий «європейський механізм запобігання аграрним кризам», який, зокрема, дозволить компенсувати збитки місцевим фермерам та землеробам. Причому відшкодування мають сягати 30 відсотків вартості непроданих продуктів за період від початку кризи і донині.
Іспанія вже заявляла декілька разів, що цього недостатньо, вона вимагатиме повної компенсації збитків, причому у Німеччини, яка раніше помилково оголосила іспанські огірки винними у поширенні інфекції. Погрожували навіть судовими позовами.
Але до всієї співдружності зверталися за відшкодуваннями й інші держави, де постраждав сільськогосподарський ринок.
«Землероби з будь-якої країни Європи, які вирощують салати, помідори та огірки, не вчинили ніякої помилки, – зауважила міністр сільського господарства Бельгії Сабін Ларуель. – І тільки тому, що Німеччина дещо непродумано забила на сполох, ми маємо сьогодні сектор економіки, що переживає величезні труднощі. Тож слід проявити повну європейську солідарність. Європа повинна бути на боці своїх землеробів».
«Слід повернути огірку його репутацію» – євродепутат
Німецький уряд того ж дня перебував під вогнем критики й у іншій установі Європи – Європейському парламенті. «Не слід було вказувати на іспанські огірки чи пророщену сою без остаточних доказів. Це тільки поширило паніку й завдало шкоди сільському господарству», – такими були висновки більшості парламентарів.
«Ми повинні бути обережними, не робити передчасних висновків, – додав єврокомісар з питань охорони здоров’я Джон Даллі, виступаючи перед депутатами. – Взяти хоча б останню інформацію з Німеччини про пророщену сою, яка могла бути джерелом зараження. Вона з’явилася, коли лабораторні тести ще не були проведені. Цих послідовних передчасних висновків слід уникати».
Походження бактерії донині залишається невідомим. Єврокомісар Даллі зауважив, що мова йде про географічно обмежений спалах, тож немає сенсу вдаватися до загальноєвропейських заходів. Головне завдання, каже він, – зупинити госпіталізації та ідентифікувати джерело цього небезпечного штаму бактерії E.coli.
Після виступу Джона Даллі слово взяв Франциско Соса Вагнер, євродепутат від Іспанії із огірком у руці. «Я люблю Німеччину, бо мій дід звідти родом. Але репутацію іспанського огірка треба відновити», – наголосив він.
Все це наслідок передчасного оприлюднення результатів пошуку джерела епідемії, викликаної невідомим донині різновидом кишкової бактерії, яка вже призвела до загибелі понад двох десятків людей.
Екстрена нарада щодо компенсацій та джерела епідемії
Тим часом, зібравшись у Люксембурзі, міністри сільського господарства ЄС шукали шляхи покращення ситуації на ринку та методи компенсації збитків, завданих овочівникам падінням попиту на їхню продукцію. Єврокомісар з питань сільського господарства й розвитку села Дачан Чолош прибув на зустріч із міністрами з пропозицією надати аграріям компенсацію у розмірі 150 мільйонів євро.
«Ми запропонували фінансовий пакет компенсації у розмірі 150 мільйонів. Після дискусій із представниками країн-членів, які попросили збільшити цю суму, я пообіцяв переглянути ці цифри й надати нову пропозицію, можливо вже завтра», – зауважив комісар.
Інша пропозиція – розширити так званий «європейський механізм запобігання аграрним кризам», який, зокрема, дозволить компенсувати збитки місцевим фермерам та землеробам. Причому відшкодування мають сягати 30 відсотків вартості непроданих продуктів за період від початку кризи і донині.
Іспанія вже заявляла декілька разів, що цього недостатньо, вона вимагатиме повної компенсації збитків, причому у Німеччини, яка раніше помилково оголосила іспанські огірки винними у поширенні інфекції. Погрожували навіть судовими позовами.
Але до всієї співдружності зверталися за відшкодуваннями й інші держави, де постраждав сільськогосподарський ринок.
«Землероби з будь-якої країни Європи, які вирощують салати, помідори та огірки, не вчинили ніякої помилки, – зауважила міністр сільського господарства Бельгії Сабін Ларуель. – І тільки тому, що Німеччина дещо непродумано забила на сполох, ми маємо сьогодні сектор економіки, що переживає величезні труднощі. Тож слід проявити повну європейську солідарність. Європа повинна бути на боці своїх землеробів».
«Слід повернути огірку його репутацію» – євродепутат
Німецький уряд того ж дня перебував під вогнем критики й у іншій установі Європи – Європейському парламенті. «Не слід було вказувати на іспанські огірки чи пророщену сою без остаточних доказів. Це тільки поширило паніку й завдало шкоди сільському господарству», – такими були висновки більшості парламентарів.
«Ми повинні бути обережними, не робити передчасних висновків, – додав єврокомісар з питань охорони здоров’я Джон Даллі, виступаючи перед депутатами. – Взяти хоча б останню інформацію з Німеччини про пророщену сою, яка могла бути джерелом зараження. Вона з’явилася, коли лабораторні тести ще не були проведені. Цих послідовних передчасних висновків слід уникати».
Походження бактерії донині залишається невідомим. Єврокомісар Даллі зауважив, що мова йде про географічно обмежений спалах, тож немає сенсу вдаватися до загальноєвропейських заходів. Головне завдання, каже він, – зупинити госпіталізації та ідентифікувати джерело цього небезпечного штаму бактерії E.coli.
Після виступу Джона Даллі слово взяв Франциско Соса Вагнер, євродепутат від Іспанії із огірком у руці. «Я люблю Німеччину, бо мій дід звідти родом. Але репутацію іспанського огірка треба відновити», – наголосив він.